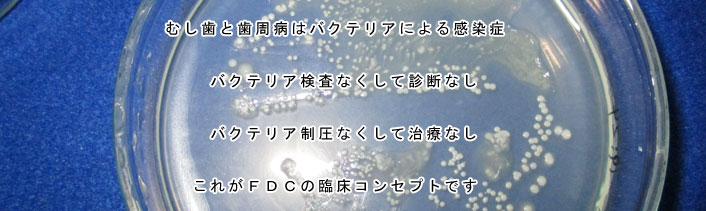
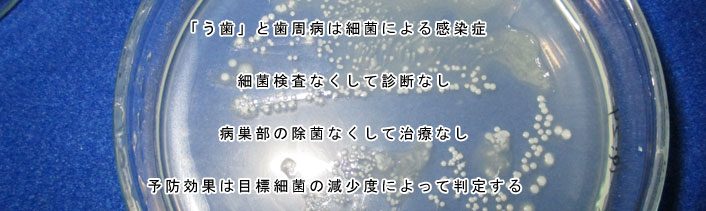

FDCの受診を希望される皆様へ
FDCは2025年10月1日より保険診療を越えた次世代型の
医療システムに変更いたします。
「名医に頼らず、自分の歯は自分で護る」
- ● 歯を大切にされている方は治療より予防、さらに遺伝子工学、ナノテクノロジーの導入により「未病」を目標にします。
- ● 現在の修復物に納得されていない方は臨床経験50年の経験知と統合型品質管理(TQC)に基づいたハイスペックの咀嚼ツールを提供します。
- ● 「正確な診断」に基づいた個人別の「歯科医療情報」を提供します。
FDCは歯で真剣に悩んでいる方に最適のソリューションを 提供できると自負しています.
院内の感染防止対策
以下の感染防止策は「COVIC-19」のためだけではなく、抗菌剤耐性菌や歯科薬剤耐性菌などの院内感染防止業務として今後も実施致します。
- 感染対策の2原則
-
ウィルスを外部から持ち込まない、院内に存在させない。
- A.接触(交差感染を含む)感染対策
- B.空間のウィルス感染対策・・・口腔内バキュームだけでは不十分
- ※診療器材の滅菌は省略
A-1 手指消毒(来院直後の手指消毒にご協力下さい)

A-2 ドアの消毒(被覆フィルムを交換)

B-3 待合室、診療室(レッドゾーン)の空間浮遊極微粒子の測定

B-4 オゾンガスモニター

A-3 防護服、防護面による診療





-
Scientific treatment principle of FDC
-
Regular checkup -
The necessity of bacterial examination
-
About bacteria
-
Bacterial culture test
-
The world of phase contrast microscopy. -
Laser treatment&Treatment cases
-
Treatment for loose teeth by periodontal disease
-
Criteria for extracting teeth
-
Advanced integrated medical information system.
-
High standard prosthesis.(Electromyogram /Pronunciation analysis ) -
Safety management
-
Infection control technology.
-
Technical education of personnel.
-
Quality Control System.
-
Holistic Medicine.
-
Preventive training program.
-
Dental information for patients.
-
Patient's evaluation.
-
FDC's mental and physical health method.
-
For FDC patients only.
- Profile of the director
-
About Disclaimer.